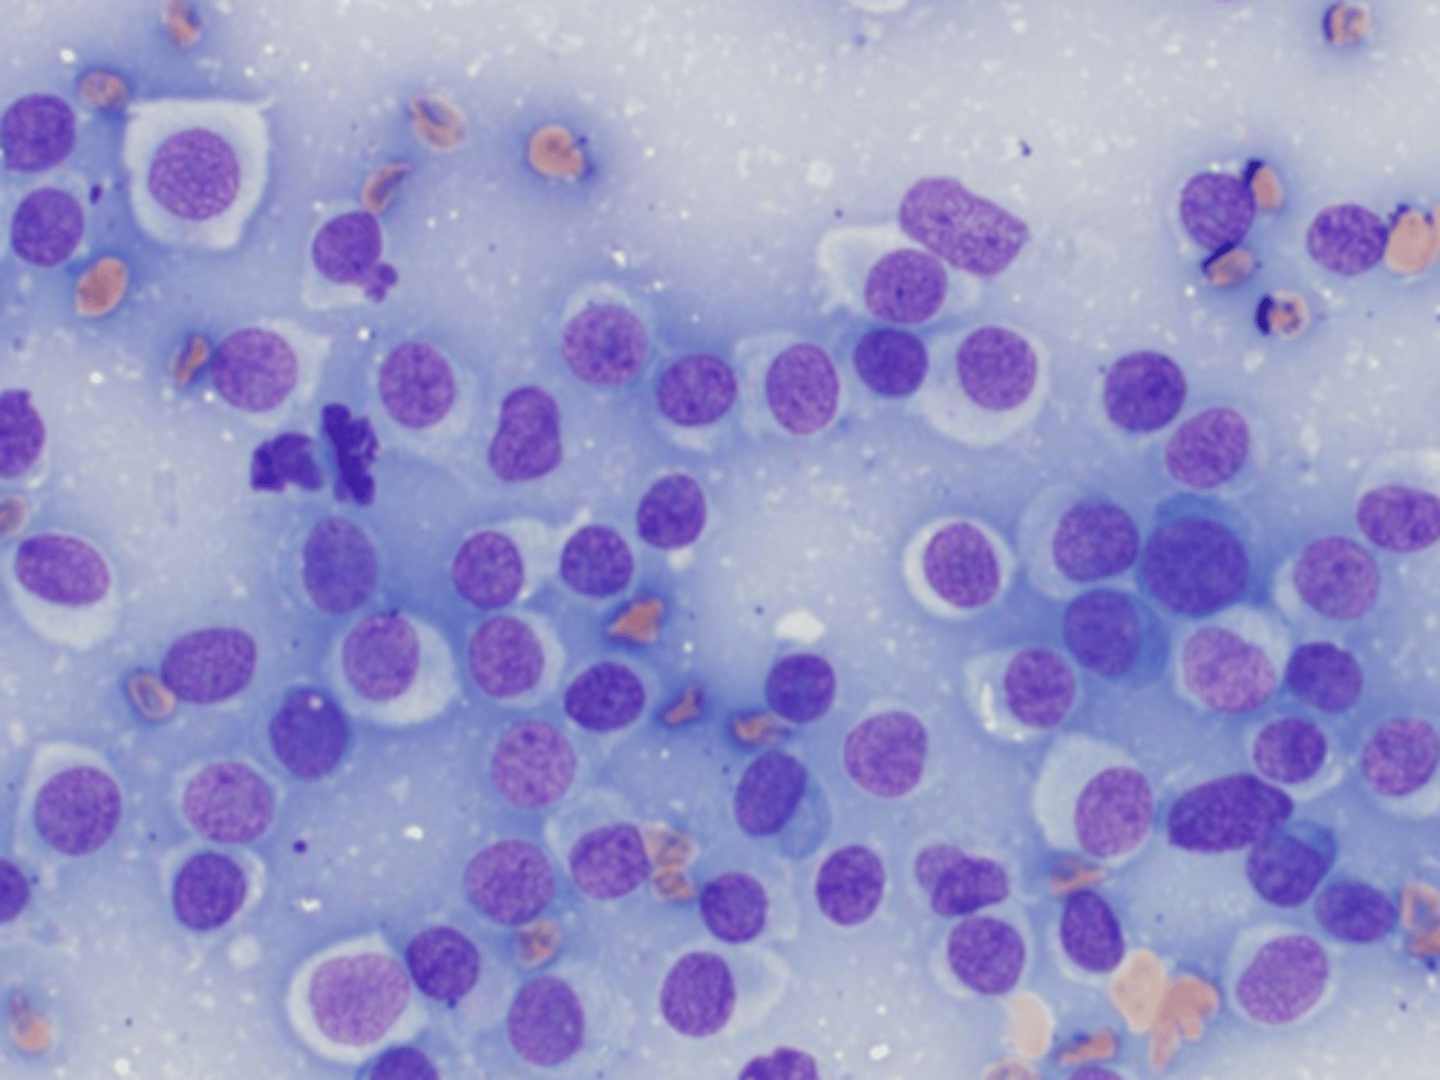
<p>Identify the type of round cell neoplasia?</p>

Cytology
1/21
There's no tags or description
Looks like no tags are added yet.
Name | Mastery | Learn | Test | Matching | Spaced | Call with Kai |
|---|
No analytics yet
Send a link to your students to track their progress
22 Terms
What are limitations of cytology?
May not be representative (not all cells collected)
Artifacts

The following is an example of what?
Artifacts
-Lysed/ damaged
-Formalin vapors
-contaminated stains
-Ultrasounds gel
-Stains precipitates

What are examples of degenerative lesions?
Hematoma, Seroma, cysts - typically in macrophages
Neutrophilic inflammation typically occurs w/ what?
Bacteria - cocci/ rods or mycobacterium and filamentous
We typically see pyogranulomatous inflammation w/ what organisms?
Mycobacterium/ filamentous bacteria
Fungi
We typically see Eosinophilic inflammation w/ what organisms?
Parasites

Identify the organism?
Fungal hyphae

Identify the organism and the size?
Malassezia pachydermatis - 3x6microns
-skin infections

Identify the organism and the size?
Sporothrix schenckii - 3-9microns
-nodular skin dz

Identify the organism and the size?
Histoplasmosis capsulatum - 2-4microns
Systemic lesions

Identify the organism and the size?
Cryptococcus - 40 microns
Nasal cavity and CNS lesion
Narrow based budding

Identify the organism and the size?
Blastomyces dermatitdis
- 8-20 microns
Systemic lesions

Identify the organism and the size?
Coccidioides -10-200microns
Systemic lesions

Identify the type of tissue?
Epithelial
-High cellularity
-Clumps/ cluster
-Well defined boarders

Identify the type of tissue?
Mesenchymal Tissue
-Individual spindled and stellate cells
-Indistinct cell boarder
-Extracellular matrix

Identify the type of tissue?
Hemic tissue
-High cellularity
-Round discrete cells
-High N:C ratio
What is the difference between a reactive LN than lymphoma?
Lymphoma has more homogenity in cells b/c one cell line is proliferating
Reactive LN has variation in cell sizes and maturities

Identify the type of round cell neoplasia?
Transmissible Venereal tumor
-Face/ genitalia area

Identify the type of round cell neoplasia?
Lymphoma

Identify the type of round cell neoplasia?
MCT - Eosinophilic w/ granules

Identify the type of round cell neoplasia?
Plasma cell tumor - basophilic cytoplasm and perinuclear clear zone
Identify the type of round cell neoplasia?
Histiocytoma - young dog spontaneously regress